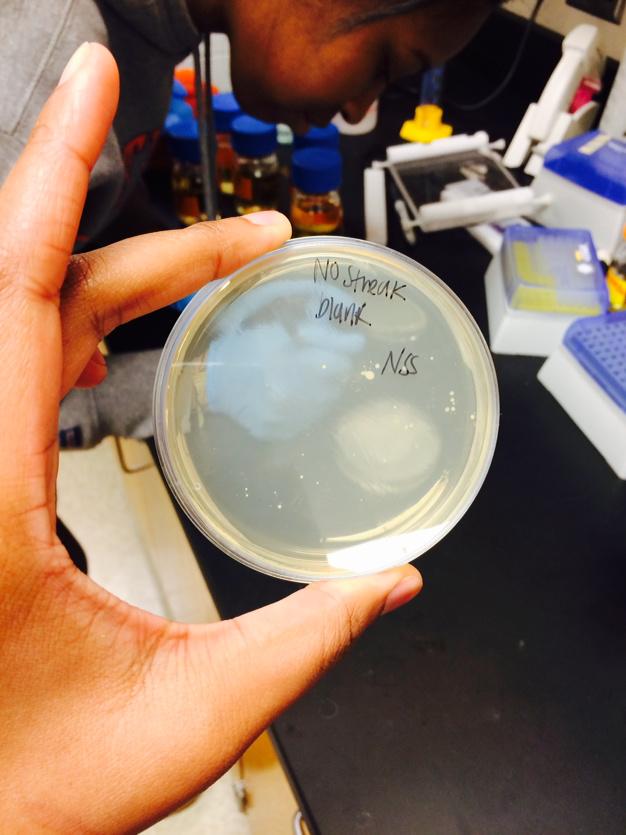
zsaidso's tweet image. As you can see, Nene is learning about sterile technique the hard way! #negativecontrol #lab #gettysburgreat

#negativecontrol search results
As you can see, Nene is learning about sterile technique the hard way! #negativecontrol #lab #gettysburgreat

When you used the incorrect antibiotic #PositiveResults #NegativeControl #NotResistence #PosDocAdventures hahaha

Anytime you don’t have “eyes on” your property you have #negativecontrol Take the extra min to do a quick sweep of your vehicle before you drive off. Doesn’t hurt to give your home a quick #walkthrough when you arrive as well. Stay #safeandsecure
4) "minority shareholder's power to #veto extraordinary actions outside ordinary course of business-such as issuance of additional stock, amend charter or bylaws, or entry into a substantially different line of business-doesn't necessarily constitute ‘#negativeControl.’"
4) More recently, #SouthernContracting (2018): "#NegativeControl exists when a minority owner can block ORDINARY ACTIONS essential to operating the company" govt.westlaw.com/sbaoha/Documen…)
2) "The text of 13 CFR §121.103(a)(3) does not provide detailed guidance about what constitutes #negativecontrol, other than mentioning that preventing a quorum or having the ability to block action by the board of directors & shareholders is relevant" govt.westlaw.com/sbaoha/Documen…)
6) "Adding new members and dissolving the concern has been found to be an extraordinary action." (i.e., not a #NegativeControl) citing the #Carntribe case (2012)
8) "OHA has also characterized a number of actions as essential to the daily operation of the company, and therefore granting a minority owner the power to block such an action constitutes #negativeControl."
10) Southern case holding: "remand the matter to the Area Office for a new size determination, that will NOT find Mr. Barlow to have #NegativeControl over EML, but will consider whether EML is affiliated w/any concerns Mr. Barlow controls under the common management regulation."
5)"minority owners...ability to block certain extraordinary actions...has not provided #negativeControl...if those supermajority provisions are crafted to protect the investment...not to impede the majority's ability to control...operations or to conduct...business as it chooses"
guidance just issued from @nvca on #protectiveProvision #NegativeControl amendments and waivers...see their site
when evaluating #protectiveProvisions in #SBALoans context, note: "finding of negative control here is not a presumption, and the regulation does not permit a rebuttal of a finding of negative control" Section 103; see, e.g., govt.westlaw.com/sbaoha/Documen…
And in the spirit of international co-operation and human advancement, we need to declare a “World Day for the Mutual Understanding and Progress of CBD Pharmacology” ... maybe Feb 29 ... @samuel_b_phd @MarikaHeblinski @mqzspa @PhD_in_Pot @rhyscohen #25v37, #negativecontrol
Belíssima banda com vocal feminino! #NegativeControl instagram.com/p/BDI8_jfuGA0/
Doing a Ca fluo3 expt., not seeing any Ca signal... changed all the settings b4 realising I had forgotten to add the fluo3 #NegativeControl
"Governments want to shape and control the public conversation, and will use every method at their disposal to do so, including the media. And the power a corporation wields to do the same is only growing. It’s critical that the people have tools to resist this."
TFW you know you’re a vassal state of the US & have no arms industry to speak of. #negativeControl on.ft.com/3OkzTl9
Let’s talk about CONTROLS. #controls are an important part of figuring out if an experiment worked as it should. When looking at a study, check to see what the #positivecontrol and #negativecontrol groups are.… instagram.com/p/CEnA5lIAmiT/…
instagram.com
I Speak Science! (@ispeakscience) • Instagram photos and videos
I Speak Science! (@ispeakscience) • Instagram photos and videos
Let’s talk about CONTROLS. #controls are an important part of figuring out if an experiment worked as it should. When looking at a study, check to see what the #positivecontrol and #negativecontrol groups are.… instagram.com/p/CEnA5lIAmiT/…
instagram.com
I Speak Science! (@ispeakscience) • Instagram photos and videos
I Speak Science! (@ispeakscience) • Instagram photos and videos
Anytime you don’t have “eyes on” your property you have #negativecontrol Take the extra min to do a quick sweep of your vehicle before you drive off. Doesn’t hurt to give your home a quick #walkthrough when you arrive as well. Stay #safeandsecure
I’m not a denier but I’d appreciate a #NegativeControl
10) Southern case holding: "remand the matter to the Area Office for a new size determination, that will NOT find Mr. Barlow to have #NegativeControl over EML, but will consider whether EML is affiliated w/any concerns Mr. Barlow controls under the common management regulation."
8) "OHA has also characterized a number of actions as essential to the daily operation of the company, and therefore granting a minority owner the power to block such an action constitutes #negativeControl."
6) "Adding new members and dissolving the concern has been found to be an extraordinary action." (i.e., not a #NegativeControl) citing the #Carntribe case (2012)
5)"minority owners...ability to block certain extraordinary actions...has not provided #negativeControl...if those supermajority provisions are crafted to protect the investment...not to impede the majority's ability to control...operations or to conduct...business as it chooses"
4) More recently, #SouthernContracting (2018): "#NegativeControl exists when a minority owner can block ORDINARY ACTIONS essential to operating the company" govt.westlaw.com/sbaoha/Documen…)
2) "The text of 13 CFR §121.103(a)(3) does not provide detailed guidance about what constitutes #negativecontrol, other than mentioning that preventing a quorum or having the ability to block action by the board of directors & shareholders is relevant" govt.westlaw.com/sbaoha/Documen…)
guidance just issued from @nvca on #protectiveProvision #NegativeControl amendments and waivers...see their site
when evaluating #protectiveProvisions in #SBALoans context, note: "finding of negative control here is not a presumption, and the regulation does not permit a rebuttal of a finding of negative control" Section 103; see, e.g., govt.westlaw.com/sbaoha/Documen…
4) "minority shareholder's power to #veto extraordinary actions outside ordinary course of business-such as issuance of additional stock, amend charter or bylaws, or entry into a substantially different line of business-doesn't necessarily constitute ‘#negativeControl.’"
As you can see, Nene is learning about sterile technique the hard way! #negativecontrol #lab #gettysburgreat
When you used the incorrect antibiotic #PositiveResults #NegativeControl #NotResistence #PosDocAdventures hahaha

Something went wrong.
Something went wrong.
United States Trends
- 1. Good Sunday 69.8K posts
- 2. Klay 30.5K posts
- 3. #sundayvibes 5,584 posts
- 4. #AskBetr N/A
- 5. McLaren 130K posts
- 6. Full PPR N/A
- 7. Blessed Sunday 19.1K posts
- 8. Ja Morant 14.3K posts
- 9. Who Dey 8,831 posts
- 10. Beirut 6,744 posts
- 11. Florentino 34.5K posts
- 12. #FelizCumpleañosNico 5,008 posts
- 13. #FG3Dライブ 121K posts
- 14. For the Lord 30.7K posts
- 15. #sundaymotivation 3,600 posts
- 16. Tottenham 51K posts
- 17. Lando 147K posts
- 18. Christ the King 11.6K posts
- 19. King of the Universe 2,272 posts
- 20. South Asia 41.9K posts























